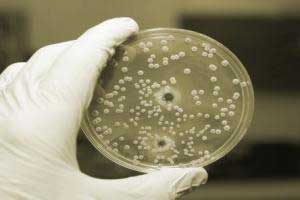

Норвегия борьба с сальмонеллезом свиней на бойнях
Может ли вакцинирование против сальмонеллы быть таким же крайне важным для свиней, каким оно является для птицы?

В настоящее время сальмонелла (Salmonella) у свиней считается, в общем и целом, одной из проблем здравоохранения. Мясо и мясные продукты, полученные из туш, зараженных сальмонеллой – основной источник инфекций человека, связываемый со свиньями, и поступление на бойню выделяющих сальмонеллу свиней является основным фактором заражения упомянутых туш. Борьба с ней на фермах носит сложный характер, комплекс мероприятий включает целый ряд действий - от ужесточения мер гигиены и биозащиты до изменений в технологии работы со стадом и используемых рационов или введения в воду или корм специальных добавок, помогающих контролировать инфекцию на интестинальном уровне (ферментированной жидкое кормление, пребиотики, пробиотики, жирные кислоты, эфирные масла и т.п.).
Тем не менее, ни одна из этих мер в отдельности не выглядит оптимальной, для более или менее приемлемого результата их всегда следует принимать совместно с другими. И новым инструментом, способным помочь бороться с этой проблемой на ферме, начинает становиться вакцинирование. На самом деле, вакцинация против сальмонеллы давно уже является ключевой стратегией по сокращению превалентности этой инфекции среди племенных кур и кур-несушек. В настоящее время превалентность инфекции среди сельскохозяйственной птицы близка к 0%, конечной задачей является ее полная эрадикация на фермах. Может ли вакцинирование против сальмонеллы быть таким же крайне важным для свиней, каким оно является для птицы?

Дело в том, что, хотя факторы риска сальмонеллезных инфекций у птицы и свиней одни и те же (ненадлежащим образом выполненная мойка и дезинфицирование между группами; зараженность корма и воды; статус здоровья животных; кросс-контаминация через зараженную обувь и инструменты; плотность животных; присутствие векторов заражения, таких, как грызуны, жуки, дикие птицы и мухи; заражение при транспортировке на бойню, и т.д.), динамика инфекции, как среди самой птицы, так и по производственным системам значительно отличается от таковой у свиней. Вертикальную трансмиссию сальмонеллы через яйца, которая является основным фактором риска, который следует иметь в виду при выполнении эрадикационных программ в птицеводстве, практически, изжили правильным проведением вакцинирования племенных кур, благодаря чему те приносят цыплят, свободных от этой инфекции. Жесткий контроль (биозащита), установленный в корпусах, где эти цыплята откармливаются, довершил дело. В итоге, в национальных программах по борьбе с сальмонеллезом в птицеводстве вакцинирование играет, наряду с биозащитой и технологией, критически важную роль.
Вакцина против сальмонеллы может использоваться для того, чтобы бороться с клинической инфекцией или чтобы снизить экскрецию этой бактерии субклинически инфицированными животными. Исследования показывают, что, в общем случае, вакцинаия эффективна при борьбе с клиническими вспышками, соотносимыми с наиболее патогенными серотипами: S. Choleraesuis и S. Typhimurium (и, возможно, из монофазными вариантами). Ситуация меняется, если наша цель - попытаться избежать экскреции на забое, для того, чтобы оградить от инфекции потребителей. В этом случае контролировать приходится большое количество штаммов и серотипов, которые зачастую относятся к антигенным группам, несовпадающим с антигеном вакцины, что делает перекрестный иммунитет проблематичным. Поэтому, в данном последнем случае упор делается на борьбе с эксрецией S. Typhimurium и ее монофазном варианте, т.е., серотипами, играющими, говоря о свиньях, более важную зоонозную роль.
Поэтому, в первую очередь следует определить, какой из этих серотипов циркулирует на ферме, а уж затем спланировать схему вакцинации. Таких схем, в зависимости от типа фермы, возрастной группы и стадии производства, существует несколько. Например: вакцинация перед опоросом, чтобы подстегнуть пассивный иммунитет поросят через молозиво; вакцинация подсосных поросят, чтобы попытаться уменьшить инфекцию при отъеме, на доращивании или даже на откорме; вакцинация животных на этапе откорма.
Общий вывод, который можно сделать – вакцинируя против сальмонеллы свиней, следует концентрироваться на несколько других вещах, нежели в птицеводстве, поскольку данная операция не дает того же самого процента снижения превалентности. Поэтому, она могла бы стать дополнением к внутрифермной программе борьбы с заболеванием, в которой количество предполагаемых мероприятий по снижению риска инфекции будет зависеть от ее превалентности и циркулирующих на ферме серотипов.
В будущем ЕС потребуется определиться с целями в отношении снижения случаев сальмонеллёза у свиней для каждой страны в зависимости от их исходного положения.
С момента публикации в 2003 году Регламента (EC) №. 2160/2003 по контролю сальмонеллы и других зоонозных агентов, ЕС определил обязательство реализации специальных программ по мониторингу и контролю сальмонеллы у домашней птицы и свиней. В то время как программы для птицеводства были реализованы чуть позже и получили очень хорошие результаты, в случае свиней мы ждём возобновления вышеуказанного Регламента и установления целей ЕС в отношении сокращения частоты заболеваний. И это при том, что многие страны, и среди них основные производители свиней, уже пошли вперёд и реализуют что-то вроде программы по мониторингу и/или контролю.
Ввиду этой ситуации является очевидным, что испанский свиноводческий сектор должен будет принять меры за короткое время по этому вопросу, если он не хочет рисковать своим экспортом. Многие вопросы ставятся перед лицом начала любой крупномасштабной инициативы, касающейся контроля сальмонеллёза. Эта статья суммирует основные стратегии действий, особенно на уровне фермы, сопровождаемые различными текущими программами по мониторингу и контролю сальмонеллёза в ЕС.


Подход в программах контроля сальмонеллеза
Европейская стратегия мониторинга и контроля Сальмонеллы, в отличие от той, которой следуют на протяжении многих лет в США и которая основана на предпринимаемых мерах (в основном дезинфекции) на бойне, в основном базируется на мерах, предпринимаемых на фермах, хотя в последнее время особое внимание также стало уделяться скотобойням после усиления контроля сальмонеллы в тушах животных (Регламент ЕС № 217/2014 от 7 марта 2014 г.).
Не смотря на то, что в некоторых странах, эти программы были начаты правительством, но по состоянию на сегодняшний день большинство из них стали инициативой со стороны свиноводства, и они налагают некоторые штрафы, или они следуют политике стимулирования.
![]()
Штрафы: это случай с Данией, где штраф экономического характера в размере 2% от стоимости туши применяется для уровня ферм второго уровня (средний показатель серопревалентности) и от 4% до 8% для ферм третьего уровня (высокий показатель серопревалентности).- Стимулы: есть несколько стран, которые создали схемы обеспечения качества, как, например, Германия (Качество и Безопасность), Соединённое Королевство (Британское гарантированное качество свинины), Ирландия (Схема обеспечения гарантированного качества) и Нидерланды (Нидерландские свиньи).
Основные элементы программ контроля на фермах
В ЕС мы находим два вида самых различных ситуаций в зависимости от уровня распространённости инфекции на свинофермах, и они определяют цели, преследуемые различными программами контроля. В Швеции, Финляндии и Норвегии, уровень распространённости очень низкий, и их программы управляются ликвидационной стратегией. Этой стратегии нельзя следовать в остальных европейских странах, в которых уровни распространённости являются средними и высокими. Таким образом, целью большинства европейских программ мониторинга и контроля сальмонеллёза у свиней является снижение уровня инфицирования насколько это возможно.
Что касается основных элементов, которые являются частью различных программ, и, принимая во внимание то, что каждая из них имеет свои особенности, мы, грубо говоря, могли бы обобщить их следующим образом:
1. Предпринимаемые меры на двух уровнях: фермы и скотобойни
Согласно датским моделям считается, что программы контроля, ориентированные исключительно на фермы, являются недостаточными для снижения уровня заражения туш животных, вызванного Сальмонеллой ниже 1% (Баптиста и др. 2011). Как только распространённость инфекции в хозяйствах снижается до определенного уровня, то это станет тем моментом, когда совместно с мерами на скотобойнях мы могли бы получить лучшие результаты с точки зрения затрат и эффективности.
2. Непрерывный мониторинг инфекции и её классификация на фермах
Учитывая большую сезонную изменчивость сальмонеллезы у свиней, мониторинг должен осуществляться всё время. Этот мониторинг может быть серологическим (образцы крови и/или мясной сок), что позволяет классифицировать различные фермы по отдельным категориям и воздействовать на тех, у которых высокий риск заражения (с более высокой распространённостью).
Но в настоящее время.
…Соединённое Королевство приостановило серологический мониторинг животных, потому что это переопределяет их программу контроля.
…в Ирландии не проводится больше классификации ферм по трём категориям, но присваивается уровень распространённости.
3. Определение приоритетов контроля на стадии откорма
До настоящего времени на начальных этапах всех программ меры санитарно - эпидемиологического надзора в основном осуществлялись на стадии откорма, хотя позже, как и в случае с датскими и ирландскими программами, свиноматочные фермы были также включены.
4. Реализация индивидуальных планов контроля на фермах
На фермах с более высоким уровнем инфицирования, как только факторы риска определяются (через детализированный перечень контрольных показателей), и проводится бактериологическое исследование распространённых штаммов, ветеринарный врач фермерского хозяйства реализует индивидуальный план контроля.
Далее мы представляем сводную таблицу основных особенностей предпринимаемых мер на стадии откорма из программ контроля сальмонеллёза у свиней в Дании, Ирландии, Великобритании, Германии и Нидерландах. Независимо от этих стран в Австрии осуществляется региональная программа контроля, а в Бельгии, Франции, и в последнее время в Каталонии, мы можем найти несколько пилотных исследований. В частности, каталонский кластер свинины INNOVACC ведёт пилотное исследование для осуществления добровольной программы по контролю свиного сальмонеллёза, которое в этот момент делает ставку на участие в ней значительного числа хозяйств и скотобоен в Каталонии и некоторых в Арагоне. Без сомнения, все эти инициативы обеспечат хорошую основу для реализации будущих программ контроля сальмонеллы в этих странах.
Таблица 1. Надзорные меры на стадии откорма из основных программ контроля сальмонеллёза у свиней в Европейском Союзе
| Страна | Сбор образцов | Серологический мониторинг | Классификация | |||
| Образец | Количество/год | Спецификация образцов твёрдофазного иммуноферментного анализа (тИФА) | Процентный порог* | Регулярность | Категории | |
| Дания | Мясной сок | 60-100¹ | Смесь образцов со всей Дании для тИФА | ≥ 20% | Ежеквартально (взвешенно: 3:1:1) | 1 ( 20% до ≤ 40%) 3 (> 40%) |
| Нидерланды | Кровь | 36 | Не указана | ≥ 40% | Ежеквартально | Соответствует программе Германии |
*Процентный порог, с которого образец считается положительным
1 В зависимости от количества животных, отправляемых на бойню ежегодно: 60 (2000 5000 свиней)
Под конец в качестве заключения мы должны отметить, что в соответствии с ранее упомянутым Регламентом (ЕС) № 2160/2003 в будущем ЕС придётся определить свои цели по сокращению сальмонеллёза в каждой стране в зависимости от её исходного положения. Кажется очевидным, что эта начальная ситуация будет определена по итогам контрольных исследований Европейского Сообщества, проведённых в 2006-2007 (Европейское управление безопасности пищевых продуктов, 2008). Очень вероятно, что способ достижения этих целей, останется за каждой страной в зависимости от своей производственной структуры; другие аспекты, но, конечно, некоторые или все основные пункты, проанализированные здесь, будут приняты во внимание. Роль скотобоен, безусловно, будет важна для избегания того, чтобы инфекция попадала к потребителю и для того, чтобы гарантировать, таким образом, конечный успех этих программ.
Сальмонеллез (Salmonellosis) заболевание вызываемое бактериям рода Сальмонелла протекающее в острой или затяжной формах, что грозит все большей проблемой, так как сальмонеллез рассматривается как зооноз. Заболеваемость в стаде может достигать 10-50%, а падеж 5-10%.
Этиология. Болезнь вызывают сальмонеллы серотипа S. choleraesuis. Другие серотипы сальмонелл, в том числе. S. typhimurium, могут также быть причиной клинической формы сальмонеллеза. В США у 90% убитых на бойнях свиней в лимфатических узлах, миндалинах и в кале обнаружены S. typhimurium. В нашей стране также все чаще обнаруживается этот тип сальмонелл. Сальмонеллы характеризуются высокой устойчивостью во внешней среде. В навозе или в корме могут неделями оставаться жизнеспособными. В мясной муке они сохраняются несколько месяцев с момента приготовления. Сальмонеллы устойчивы к замораживанию и высыханию.
Эпизоотологические данные. Сальмонеллез проявляется, главным образом, у свиней в возрасте 10 — недель, находящихся в плохих условиях содержания, и бывает в форме сепсиса, острого гастроэнтерита в хронической форме. Все чаще наблюдается легочная форма сальмонеллеза. На многих фермах сальмонеллез проявляется энзоотически при ухудшении условий выращивания, особенно отнятых поросят. Частота заболевания сальмонеллезом зависит от многих факторов (скученность, плохая вентиляция, частая перегруппировка). Использование антибиотиков ограничивает заболеваемость и падеж животных, но не исключает и даже удлиняет период носительства и распространения сальмонеллы. Патогенез Инфицирование происходит лет возникновения болезни имеет значение доза бактерий. Главным патологическим процессом является сепсис. В патогенезе играет роль эндотоксин, повреждающий клетки важных органов, вызывая их воспаление и дисфункцию. Воспалительные изменения концентрируются, главным образом, в желудке и в тонком кишечнике, а при хронической форме в толстом кишечнике.
Клинические признаки. Первый признак болезни водянистая диарея с калом желтого цвета без примесей крови и слизи. Она длится 3-5 дней и имеет тенденцию к рецидиву. Болезнь за несколько дней охватывает большинство свиней в загоне. Сальмонеллез чаще всего обнаруживается у подсвинков и свиней на откорме до пятого месяца жизни. Заболевание может проявляться даже у животных основного стада. В таких случаях могут быть внезапный падеж и аборты. Заболеваемость сальмонеллезом достигает 80 90%, а падеж до 20%. При острой форме температура достигает -1. 0 С. отмечаются диарея, вялость. Характерным является покраснение кожи в области ушей, брюха и на внутренних поверхностях бедер. Отмечается быстрый падеж свиней с синением ушей и кожи живота. При затяжной форме боле кроме падежа и изнуряющей диарее могут быть запоры, хронически мягкий кашель и наблюдаемые после перегонов, затруднения при дыхании. Легочная форма развивается при заражении через нос S. Cholerae suis или в результате сепсиса. Во многих странах, в том числе и в нашей стране воспалительные изменения в легких доминируют над изменениями в пищеварительной системе. Клинические признаки в этих случаях напоминают плевропневмонию. Выздоровевшие особи остаются носителями сальмонеллы не менее пяти месяцев. Патологоанатомические изменения На вскрытии обнаруживают посинение кожи, отек селезенки, цвет которой может темно-голубым. На почках могут быть точечные некрозы, в желудке и тонком кишечнике геморрагическое воспаление и гипертрофия слизистой оболочки, а также заметное увеличение лимфатических узлов. При подострой и хронической форме наиболее характерным признаком бывает ложнодифтеритическое воспаление толстого, а иногда и тонкого кишечника. На слизистой оболочке заметны налеты серо-желто-зеленого, коричневого цвета, под налетом обнаруживаются язвы с уплотненными краями. Лимфатические узлы брыжейки сильно увеличены. При легочной форме сальмонеллеза (pneumoparatyfus), которая встречается довольно часто, обнаруживается катаральная пневмония, легкие приобретают серо-красную окраску. Может развиваться крупозная пневмония или гнойное перибронхиальное воспаление легких на фоне S. typhisuis.
Взятие и пересылка материала для исследований. Для бактериологических исследований берут мазки из прямой кишки (желательно от большей части свиней). Ценным диагностическим материалом являются миндалины и желчный пузырь, где сальмонеллы находятся дольше всего. Образцы следует брать от нелеченных и только что павших животных.
Меры борьбы. При появлении в стаде сальмонеллеза прежде всего надо определить серотип микроба. Больных свиней надо лечить химиопрепаратами согласно антибиотикограмме. Исследования показывают, что наиболее эффективными являются энтрофлоксацин (Байтрил, Энробиофлокс. Энроксил), норфлоксацин (Квинабик, Hopmpia апрамщин. В настоящее время наиболее эффективным препаратом для лечения сальмонеллеза является энрофлоксацин в дозе 5 мг кг массы животного в течение пяти дней. Неэффективны при сальмонеллезе стрептомицин, тетрациклины, сульфаниламиды. Важную роль в борьбе с сальмонеллезом играют подкислители (Аиидпак, молочная кислота и т. д.), их следует использовать в максимальных дозах. Эффективна и специфическая профилактика сальмонеллеза. Недопустимо кормление свиней кормами, контаминированными сальмонеллами. Для исключения этого необходимо проведение бактериологического исследования промышленных кормов. Контаминированные корма надо подвергать термической или химической обработке. Необходимо регулярно дезинфицировать помещения фермы. Для этого рекомендуется Сталозан Ф или Дезосан в дозах 50 г/1м2. Принимая во внимание роль грызунов (крыс, мышей) в распространении сальмонеллеза, необходимо проводить периодическую дератизацию.

Сальмонеллез — инфекционная болезнь, поражающая преимущественно молодняк до 4-5-месячного возраста (поросят-сосунов и отьемышей), сопрождающаяся расстройствами желудочно-кишечного тракта и септицемией. У взрослых свиней болезнь протекает как сопутствущая инфекция на фоне кормовых интоксикаций, чумы и других болезней.
Этиология. Заболевание у свиней вызывают в основном следующие виды сальмонелл: сальмонелла холерасуис, сальмонелла энтеритидис, сальмонелла тифимуриум и сальмонелла тифисуис. Сальмонеллы представляет из себя — маленькие палочки (1-4* 0,5мкм), с закругленными концами, грамотрицательные, подвижные, спор и капсул не образуют. Во внешней среде довольно устойчивы- сохраняясь на объектах внешней среды до 160дней, в навозе-420 суток, в воде- свыше 500 суток, в соленом и копченом мясе- 2,5-3месяца, в замороженном состоянии в течение 4-5месяцев, на солнечном свете до 150дней, при нагревании до 70-75 градусов инактивируется за 15-30минут. При биотермическом обеззараживании в навозе инактивируется в течение трех недель. Бактерии неустойчивы к дезинфицирующим средствам : 4% раствор едкого натра, хлорная известь содержащая 4% активного хлора, 20%-ная взвесь свежегашеной извести, 1%-ный раствор карболовой кислоты и креолина.
Эпизоотология. Возникновению сальмонеллеза в хозяйстве способствуют антисанитарные условия содержания поросят (неудовлетворительный микроклимат в свинарнике), а также скармливание недоброкачественных кормов, наличие у свиней других заболеваний. Поросята сальмонеллезом заболевают с первых дней жизни до 4-х месячного возраста, но эпизоотии у поросят чаще возникают после отъема. Первые случаи заболевания поросят сальмонеллезом на свинарнике в основном зависят от ослабления устойчивости молодняка в результате неудовлетворительных условий кормления, ухода и содержания. Вначале заболевают слабые, недоразвитые поросята. По мере пассажа, вирулентность возбудителя усиливается и начинает заражаться нормальный молодняк.
Источником сальмонеллеза являются больные поросята, а также переболевшие животные-бактерионосители и их экскременты. Особую опасность на свинарнике представляют подсосные свиноматки-бактерионосители, когда сальмонеллезная инфекция, возникнув в пометах таких свиноматок, распространяется на другие пометы. Свою роль в распространение сальмонеллеза на свинарнике играют дикие голуби, воробьи, кошки и грызуны, которые могут болеть сальмонеллезом и служить механическими переносчиками сальмонеллеза. Заражение поросят происходит алиментарным путем через пищеварительный тракт при употреблении инфицированного корма, воды, молока, а также корма животного происхождения (мясо-костная и рыбная мука, необезвреженные боенские отходы обсемененные сальмонеллами). Свиноматки могут заражаться при поедание грызунов больных или павших от сальмонеллеза. Человек может заразится сальмонеллезом при употреблении мяса или мясных конфискатов от животных-сальмонеллоносителей. Особую опасность в возникновении болезни представляет ввод на ранее благополучную свиноферму свиней — бактерионосителей. Продолжительность бактерионосительства у свиней более года.
Сальмонеллез принято подразделять на первичный, типично протекающий для данного вида животных, и вторичный — как осложнение при инфекционных и незаразных болезнях. На практике бывают случаи осложнения сальмонеллезом — чумы, пастереллеза, дизентерии, рожи свиней, оспы и болезни Ауески.
Патогенез. Сальмонеллы попав поросятам алиментарным путем (с молоком, кормом, водой и пр.) нарушают целостность слизистой оболочки кишечника и проникают в кровь. Попав в кровь, они повреждают стенку сосудов, в результате чего происходит выход эритроцитов в окружающие ткани, развиваются экссудативные процессы. Одновременно сальмонеллы и их токсины оказывают воздействие на центральную нервную систему, вызывая в ней токсико-дистрофические изменения, приводя в итоге к нарушению функции всего организма.
Клинические признаки. Болезнь может протекает у поросят остро, подостро и хронически. У поросят-сосунов сальмонеллез обычно протекает остро, у поросят послеотъемного периода — подостро или хронически. У взрослых свиней сальмонеллез протекает латентно.
Инкубационный период — от 3 до 20дней. У поросят-сосунов он короче, у отъемышей — продолжительнее.
Первые случаи сальмонеллеза на свинарнике обычно протекают остро. Заболевание сопровождается повышением температуры тела до 42 градусов, у поросят сосунов отсутствует сосательный рефлекс, у поросят более старшего возраста наблюдаем отказ от корма. Такие заболевшие животные зарываются в подстилку, тяжело дышат, появляется коньюктивит. Вскоре у больных поросят появляется понос, при котором фекалии становятся жидкими, грязно-серого цвета, иногда с примесью крови и имеют зловонный запах. У отдельных больных поросят отмечаем коликообразные боли, при которых поросята ложатся на грудь, поджимают под себя задние ноги и вытягивают передние. Кожа ушей, нижней части груди, живота вследствие сердечной слабости и нарушения кровообращения перед летальным исходом становится темно- фиолетового цвета. В 50-80% случаев на 3-7-й день болезни поросята погибают.
Подострое течение болезни бывает у поросят заболевших спустя некоторое время после начала вспышки сальмонеллеза на свинарнике. У таких поросят заболевание начинается с ухудшения аппетита, они меньше двигаются, стараются забиться в угол, температура тела повышается до 41градуса. У больных поросят отмечаем понос, фекалии имеют грязно-серый цвет с пузырьками газа, зловонного запаха, часто понос чередуется с запорами. За 15-20дней болезни поросята становятся худыми, кожа у них становится серой, собирается в складки и покрывается грязными корками. У поросят развивается синюшность подгрудка, живота, промежности и ушей. У отдельных поросят приходится наблюдать омертвение и отпадание кончика ушей, хвоста и развитие пневмонии. При такой форме болезни у 40% животных наступает смерть. Поросята оставшиеся в живых отстают в росте и развитии.
Хроническое течение болезни проявляется преимущественно у поросят старшего возраста. Течение болезни характеризуется менее выраженными клиническими признаками и более длительным течением. Болезнь продолжается от нескольких недель до трех и более месяцев. У больных животных температура тела редко поднимается выше 40 градусов, понос часто сменяется запором. В фекалиях нередко удается обнаружить примесь слизи и крови. У таких поросят часто развивается воспаление легких, поросята тощают, кожа становится серой, анемичной, собирается в складки. На коже нередко развивается струпьевидная экзема (оспоподобная сыпь). Заболевшие поросята отстают в росте и выглядят заморышами. Большинство из них гибнет.
У взрослых свиней болезнь протекает латентно, без ясно выраженных клинических признаков. Болезнь длится 5-8 дней и обычно заканчивается выздоровлением. У свиноматок снижается плодовитость, иногда бывают аборты, поросята рождаются маложизнеспособными. У подсосных свиноматок бывает агалактия. Такие переболевшие свиноматки на свиноферме длительное время являются бактериовыделителями.
Патологоанатомические изменения зависят от возраста животных и длительности течения болезни.
При остром течении отмечаем картину септицемии. Геморрагические явления выражены не резко: встречаем кровоизлияния на слизистой оболочке желудка, кишечника. На эпи- и эндокарде, на серозных покровах селезенки, печени, почек. Селезенка несколько увеличена, плотновата сине-красного цвета, фолликулы на разрезе увеличены. Печень увеличена в объеме. Застойно полнокровна, местами сероватого цвета. Почки-застойная гиперемия и зернистая дистрофия. В желудке и тонком кишечнике находят острое катаральное, в отдельных случаях переходящее в геморрагическое воспаление, пейровые бляшки и солитарные фолликулы набухшие. Мезентериальные лимфатические узлы увеличены, набухшие, серо-красного цвета, на разрезе сочные. В сердце-расширение правого отдела, зернистая дистрофия миокарда. В легких — острая застойная гиперемия и отек.
В свежих случаях при диффузных поражениях слизистая оболочка покрывается мелким отрубьевидным налетом. В дальнейшем, в связи с инфильтрацией стенки кишки фибринозным экссудатом и глубоким некрозом слизистой, кишечник превращается в малоподвижную трубку, внутренняя поверхность которой покрыта мощными, иногда крошковатыми серовато-желтыми с зеленоватым оттенком дифтеритическими наложениями.
Дифтеритические струпья и язвы обнаруживают в желудке и миндалинах. Селезенка увеличенная, плотная, серовато-вишневого цвета. Печень увеличена, дряблая, серовато-красного или глинистого цвета с поверхности и в глубине печени, как и при сальмонеллезе телят. Находим милиарные некрозы и паратифозные узелки. При поражение легких находим катаральную или хроническую катарально-гнойную бронхопневмонию.
Диагноз ставят на основании эпизоотологических данных, симптомов болезни, патологоанатомических изменений, и результатов бактериологического исследования. Для бактериологического исследования на сальмонеллез в ветлабораторию посылают свежие трупы или паренхиматозные органы (печень с желчным пузырем и лимфатическими узлами, селезенку и почку), мезентериальные лимфатические узлы, трубчатую кость, а в случае аборта — плод.
Дифференциальный диагноз необходимо исключить чуму, дизентерию, колиинфекцию, диплококковую инфекцию и отравления.
Лечение. Больных сальмонеллезом поросят лечат иммунной сывороткой в сочетании с подтированными антибиотиками. При лечении хорошие результаты дает левомицетин в дозе 30-40мг на 1кг массы тела животных 2раза в день, а также тетрациклин в той же дозе.Их задают больным поросятам на протяжении 4-6дней. Для лечения применяется также неомицин, фуразолидон. Хорошие результаты дает совместное применение антибиотиков и сульфаниламидных препаратов (сульфадимизин, этазол, сульгин, норсульфазол и др.).
В последнее время промышленность выпускает современные антибактериальные лекарственные средства широкого спектра действия, которые оказывают быстрое бактерицидное действие и хорошо распределяются в тканях больного поросенка. К таким лекарственным средствам относится КЛАМОКСИЛ ЛА, который вводится поросенку внутримышечно в дозе 1мл на 10кг массы тела животного. При наличии показаний препарат вводят повторно через 48часов. ТЕРРАМИЦИН ЛА— также обладает широким спектром действия, максимальная концентрация после его введения в крови уже наступает через 30минут, терапевтическая концентрация в крови и тканях-96часов. Курс лечения — одна иньекция. Препарат применяют однократно глубоко внутримышечно в дозе 1мл на 10кг массы тела животного.
Иммунитет. Установлено, что свиньи переболевшие сальмонеллезом, повторно им не заражаются т.к. иммунитет при сальмонеллезе имеет антибактериальную и антитоксическую природу. Устойчивость свиней к болезни, как и при других инфекционных заболеваниях в значительной степени зависит от резистентности организма. Важным звеном в профилактике сальмонеллеза является наличие в молозиве свиноматок защитных антител (колостральный иммунитет), что используется для пероральной иммунизации всех новорожденных телят.
В России широко используется несколько вакцин против сальмонеллеза:
поросят и свиноматок вакцинируют концентрированной поливалентной формолквасцовой вакциной против сальмонеллеза, пастереллеза и диплококковой инфекции поросят. Вакцинация поросят проводится в возрасте 20-30дней двухкратно с интервалом в 5-7дней, супоросных свиноматок вакцинируем трехкратно за 15-20 дней до опороса. В неблагополучных по сальмонеллезу свиноводческих хозяйствах используют сухую живую вакцину против сальмонеллеза свиней из штамма ТС-177, а также бивалентную из штаммов с. тифимуриум №3 и с.холерасуис №9, инактивированную вакцину против пастереллеза и сальмонеллеза, предложенные ВНИИЗЖ. МГАВМи Б предложена вакцина ассоциированная инактивированная против острых кишечных заболеваний молодняка с/х животных, включающая в себя с. дублин, с.энтеритидис, с. тифимуриум.
Меры борьбы и профилактика. Профилактика сальмонеллеза поросят состоит из комплекса мероприятий куда входят: недопущение заноса возбудителя сальмонеллеза извне, создание оптимальных условий содержание и кормления животных, а также создания на свиноводческом хозяйстве надлежащего ветеринарно-санитарного режима, при угрозе заноса сальмонеллеза проведение вакцинации всего восприимчивого поголовья. Специалисты хозяйств особое внимание должны обращать на качество поступаемых в хозяйство кормов, которые подвергают бактериологическому контролю на наличие сальмонелл. Учитывая, что носителями и распространителями сальмонеллеза могут быть грызуны, то на свиноводческой ферме систематическое проведение дератизации является важнейшим звеном в профилактике сальмонеллеза. В профилактике сальмонеллеза специалисты обращают внимание на комплектование и ремонт основного стада благополучным в отношении сальмонеллеза поголовьем. С этой целью во время нахождения животных в карантине ветспециалисты хозяйства в ветеринарной лаборатории проводят исследование сыворотки крови в РА и бактериологические анализы фекалий на носительство сальмонелл.
При появлении сальмонеллеза свиноводческое хозяйство Постановлением Губернатора области обьявляется неблагополучным по сальмонеллезу. Все поросята-отъемыши и сосуны старше 1месячного возраста подвергаются клиническому осмотру с обязательной термометрией. После проведенного клинического осмотра все поголовье делится на две группы:
- Явно больные поросята с острой, подострой и хронической формой течения болезни и имеющих повышенную температуру тела.
- Поросята с нормальной температурой тела и не имеющие клинических признаков сальмонеллеза.
Животных первой группы изолируем и подвергаем лечению сывороткой, антибиотиками, сульфаниламидными и нитрофурановыми препаратами, даем ПАБК и назначают симптоматические средства.
Поросят второй группы после термометрии, применяем сыворотку и вакцинируем. При вспышке сальмонеллеза рекомендуется применять моновакцины.
Супоросных свиноматок вакцинируем за 35-45 дней до ожидаемого опороса. Холостых, ремонтных свиноматок и хряков вакцинируем не менее 2-х раз в год. Помещения свинарника ежедневно очищают и раз в неделю дезинфицируют 3%-ным горячим раствором едкого натра, 20%-ной водной взвесью свежегашеной извести или 2%-ным раствором формалина. Кормушки, ведра, поилки после каждого кормления подвергают тщательной очистке, промывают водой и просушивают. Еженедельно комиссионно отбирают поросят, отставших в росте и развитии из которых формируют отдельную группу с лучшими условиями
кормления и содержания.
Карантин с неблагополучного хозяйства снимают через 1месяц после последнего случая заболевания животных и проведения в нем заключительной дезинфекции.
Читайте также:



